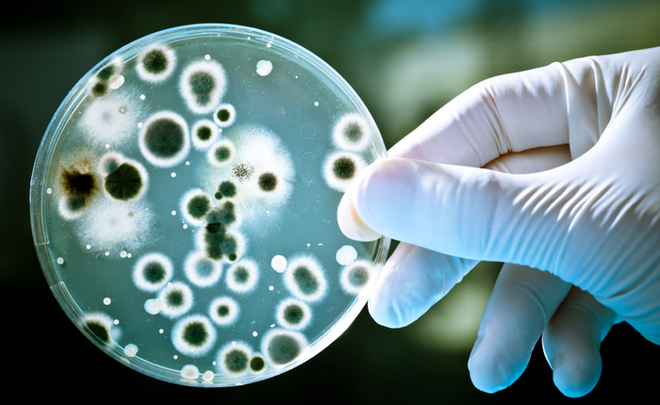

Một lần nữa, câu chuyện lạm dụng kháng sinh lại gióng lên một hồi chuông cảnh tỉnh vô cùng đáng sợ cho những người tự ý mua thuốc, dùng thuốc mà không theo chỉ dẫn của bác sĩ.
Theo chia sẻ của BS Ngô Đức Hùng (Khoa Cấp cứu A9, Bệnh viện Bạch Mai), khoa mới tiếp nhận một bệnh nhân viêm phổi vì siêu vi khuẩn từ tuyến dưới chuyển lên, kháng tất cả các loại kháng sinh hiện có trên thị trường. Đây là vấn đề nan giải vì tất cả chỉ còn trông chờ vào hệ miễn dịch của chính người bệnh, đó là hy vọng duy nhất.
Các bác sĩ cũng bó tay vì không còn loại kháng sinh hữu hiệu nào điều trị cả bởi vi khuẩn đã chống lại được hết các vũ khí của y học hiện đại. Đáng nói nhất là trường hợp này không hiếm mà gặp khá thường xuyên. Và đáng tiếc, thông thường phần thua lại nằm ở phía… nhân viên y tế.
Những con vi khuẩn này nằm lẫn mọi nơi trong đất đai quê nhà, trong nước, trên da người, tại các hốc tự nhiên trên cơ thể và loăng quăng trong không khí.
Siêu vi khuẩn xuất hiện do lạm dụng kháng sinh – Nỗi kinh hãi của loài người vài năm trở lại đây
"Gần đây truyền thông thường nhắc đến những con vi khuẩn siêu kháng thuốc hết sức kinh khiếp như vậy. Câu chuyện này được nhắc đi nhắc lại tại các hội nghị HSCC và truyền nhiễm từ năm này qua năm khác với nỗi lo lắng khôn nguôi bởi dù không muốn, chúng ta phải thừa nhận tất cả vẫn đang là kẻ thua cuộc trong cuộc chiến với siêu chiến binh này. Chúng dường như đang lây lan khá nhanh giữa các cơ sở y tế, và biện pháp điều trị hữu hiệu hiện nay thì như ánh đom đóm giữa đêm đen", BS Ngô Hùng chia sẻ trên trang facebook cá nhân.
Theo BS Ngô Hùng, những con vi khuẩn này nằm lẫn mọi nơi trong đất đai quê nhà, trong nước, trên da người, tại các hốc tự nhiên trên cơ thể và loăng quăng trong không khí. Chúng vốn sống yếu ớt và hiền hoà cùng các loài vi khuẩn có ích khác một cách cân bằng chả hại ai bao giờ. Nhờ hệ thống miễn dịch cùng mối cân bằng tuyệt vời ấy mà cơ thể con người chúng ta sống một cách khoẻ mạnh.

Khi nhiễm bệnh, vũ khí được dùng để tiêu diệt chúng chính là thuốc kháng sinh.
"Những vi khuẩn này chỉ trỗi dậy khi cán cân bị phá vỡ vì lý do nào đó có thể biết trước, hệ miễn dịch yếu đi, bọn khốn trỗi dậy hay kẻ tử tế bị tiêu diệt. Nguồn cơn cũng chỉ do những thứ ấy", bác sĩ cho biết.
Giải pháp duy nhất để tiêu diệt vi khuẩn đang trên bờ vực thẳm vì lạm dụng kháng sinh
BS Ngô Hùng cho hay, khi nhiễm bệnh, vũ khí được dùng để tiêu diệt chúng chính là thuốc kháng sinh. Mỗi loại thuốc có cơ chế tác động tiêu diệt hay kìm hãm phát triển một vài nhóm vi khuẩn nhất định. Việc dùng bừa bãi và không hợp lý sẽ tạo điều kiện cho vi khuẩn kháng lại do nhiều cơ chế khác nhau: Kháng tự nhiên do kháng sinh đang dùng có cơ chế tác dụng chả liên quan đến chuyển hoá của nó, dùng không đủ liều. Và rồi sự đàn áp không đủ khiến các siêu chiến binh xuất hiện.
"Việc sử dụng kháng sinh không hợp lý do nhiều nguyên nhân, có thể từ nhân viên y tế, nhưng đặc biệt hiện tượng mua bán thuốc không theo đơn như hiện nay đã thúc đẩy quá trình nhờn thuốc nhanh hơn. Theo nghiên cứu công bố trên Pubmed, khảo sát tại các nhà thuốc tại Việt Nam, hầu hết thuốc kháng sinh bán đều không theo đơn mà do người bán thuốc tự bán theo… lời kể hoặc người mua tự kê. 88% ở thành thị và 91% ở nông thôn mua không cần đơn thuốc. Nhu cầu kháng sinh khi đi mua thuốc ở thành thị là 50%, nông thôn là 28%. Trong khi nghiên cứu định tính cho thấy chả ai hiểu biết gì về kháng sinh cả".

Việc sử dụng kháng sinh không hợp lý do nhiều nguyên nhân, có thể từ nhân viên y tế, nhưng đặc biệt hiện tượng mua bán thuốc không theo đơn như hiện nay đã thúc đẩy quá trình nhờn thuốc nhanh hơn.
Vị bác sĩ bày tỏ nỗi sợ hãi về một thực tế đáng sợ: "Dạo qua một vòng các trang mạng xã hội đặc biệt các mẹ bỉm sữa, việc chia sẻ các đơn thuốc tự điều trị còn sôi động và kinh khiếp hơn. Mình chụp được 1 cái ảnh trong group hướng dẫn điều trị thuốc theo… lời kể, hầu hết đều có kháng sinh mà không hiểu ra làm sao. Người ta dễ dàng khuyên nhau nên điều trị thuốc này, thuốc kia trong khi những người làm chuyên môn lại rất thận trọng trong việc tư vấn qua mạng như thế này".

Bệnh nhân đa kháng thuốc và 1 danh sách thuốc các mẹ tự làm bác sĩ truyền tay nhau trên một group bỉm sữa, có đầy kháng sinh và corticoid trong đó. (Ảnh: BS Ngô Hùng)
Và những siêu vi khuẩn kháng thuốc sinh ra từ đây. Vì các bà mẹ bỉm sữa ấy, trẻ con luôn phải hứng chịu hậu quả không đáng có. Tất cả họ hàng hang hốc ông bà cha mẹ đều quan tâm thái quá bằng cách mỗi khi con hay cháu ốm đều lên tiếng uống thuốc sao mãi không khỏi, uống thuốc này đi thuốc kia đi.
Bác sĩ khẳng định, dùng thuốc phải theo đơn. Còn với chúng ta, mấu chốt là phòng còn hơn chống, đừng tạo điều kiện cho các siêu chiến binh này xuất hiện. Việc đề phòng nhiễm khuẩn không đến nỗi phức tạp, chỉ cần vệ sinh sạch sẽ thân thể hàng ngày và tập luyện cho hệ miễn dịch đã đủ giúp cơ thể chiến thắng phần lớn các mầm bệnh.
Thêm vào đó, một động tác rửa tay đã có thể ngăn chặn sự lây lan của những bệnh nhiễm khuẩn. Rửa tay bằng xà phòng đúng cách giống như vắc-xin cho hệ miễn dịch vậy: đơn giản, rẻ tiền và hiệu quả. Những con siêu vi khuẩn sẽ chẳng bao giờ có cơ hội xuất hiện. Và chúng ta vẫn cứ sống khoẻ mạnh bằng những điều đơn giản ấy. Kháng sinh ư, hãy dùng đúng và cẩn thận!
Theo Helino
